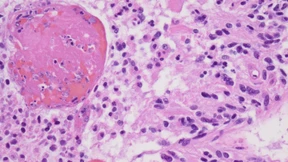
Dem Hirntumor den Strom abstellen

„Ohne Teilzeit wären wir in der Personalplanung unflexibler“
Die Pläne in der CDU, das Recht auf Teilzeit einzuschränken, sehen viele Arbeitgeber kritisch. Sie erkennen auch Vorteile, wenn Arbeitszeit reduziert wird, und haben andere Wünsche.

Die Pläne in der CDU, das Recht auf Teilzeit einzuschränken, sehen viele Arbeitgeber kritisch. Sie erkennen auch Vorteile, wenn Arbeitszeit reduziert wird, und haben andere Wünsche.

Bundesgerichtshof spricht abgewiesener Wohnungsinteressentin Schadensersatz zu. Bahnprojekt Wallauer Spange steht in den Sternen. Und der ZDF-Intendant weist Einseitigkeit seines Senders von sich. Die F.A.Z.-Hauptwache blickt auf die Themen des Tages.

Das Musical „Die Cher Show“ erzählt vom an Höhen und Tiefen überaus reichen Leben des amerikanischen Weltstars Cher. Nun ist das Stück in seiner deutschsprachigen Version in der Jahrhunderthalle Frankfurt zu sehen.

Wer wegen seines Namens keine Einladung zur Wohnungsbesichtigung erhält, wird diskriminiert und kann Anspruch auf Schadenersatz haben. Das hat der BGH nun entschieden. Viele sehen darin nun ein Urteil mit Signalwirkung.

Die Deutsche Bank legt eine gute Bilanz vor. Der Kurs der Bank ist wichtig für Frankfurt – und Europa.

Ein Spanier soll den kriselnden Fußball-Bundesligaklub Eintracht Frankfurt wieder nach vorne bringen. Mit ihm kommt eine neue Spielidee an den Main. Und ein Trainer, der nicht bei jedem beliebt ist.

Jüdisch-israelische Restaurants werden angefeindet. In Frankfurt haben Zoe Rosenfeld und Bruno Albrecht mit Hass und Boykottaufrufen zu kämpfen. Ihre Gegner werfen ihnen vor, sie bereicherten sich an der arabischen Küche.

Das Jüdische Museum in Frankfurt hat weiter stark mit antisemitischen Anfeindungen zu kämpfen. Gleichzeitig steigen die Besucherzahlen. 2026 wird der Beastie-Boys-Musiker Mike Diamond eine wichtige Rolle im Haus spielen.

Hier spielt die Musik: Mit Videokunst über Subkultur-Phänomene machen Bárbara Wagner und Benjamin de Burca Türen auf. In der Schirn Kunsthalle Frankfurt ist jetzt auch ein neues Video aus der Region zu sehen.

Frankfurt wächst weiter. Doch wie und wo sollen die dafür nötigen Wohnungen entstehen? Die Parteien haben in ihren Kommunalwahlprogrammen unterschiedliche Lösungsansätze.

Wenn in Frankfurt neue Baugebiete geplant werden, regt sich Widerstand. Bürgerinitiativen fürchten einen politischen Wechsel nach der Kommunalwahl.

Frankfurt verzeichnet weiteren Zuwachs bei den Schwimmbadbesuchen und leitet daraus Überlegungen zu den Aufgaben der Politik ab. Kommunen müssten über solche Einrichtungen Vertrauen schaffen.

Das Kommunale Wahlrecht ist verfassungswidrig. Beim Bau des Riederwaldtunnels gibt es Verzögerungen. Busfahrer in Wiesbaden fotografieren Falschparker. Die F.A.Z.-Hauptwache blickt auf die Themen des Tages.

Das Bundeskriminalamt hat Geschäftsräume des größten deutschen Geldinstituts durchsucht. Es geht um den Verdacht der Geldwäsche. Und in Kreisen fällt ein Oligarchenname: Roman Abramowitsch.

Joachim Kaufmann vom Carlsen Verlag löst ab Oktober, gleich nach der nächsten Frankfurter Buchmesse, den langjährigen Leiter Juergen Boos ab. Hat er das Zeug dazu, längst Überfälliges anzugehen?

Zwei Unbekannte sollen vor einigen Monaten in Frankfurt eine Frau vergewaltigt haben. Fotos von einem Paar, das auf dem gleichen Konzert war wie das spätere Opfer, könnten helfen, sie zu finden.

Eintracht-Rekordabgang Randal Kolo Muani schwächelt auch in England. Mit Tottenham kehrt er in der Champions League nach Frankfurt zurück. Auf der Anreise erlebt der Stürmer aber einen Schreck.

Wer Elektroroller nicht selbst nutzt, für den sind sie häufig ein Ärgernis. Dagegen helfen nicht allein Regeln. Das größte Druckmittel wäre die Haftung.

Mit 800 Beamten sind Zoll und Staatsanwaltschaft am Mittwoch gegen eine multinationale Gruppierung vorgegangen. Sie soll Schwarzarbeit im Baugewerbe im großen Stil organisiert haben. Drei Männer wurden verhaftet.

Kostbare Kunst und heiliger Müll: Die antike Stadt Nida birgt viele Überraschungen. Nun steht gut eine Million Euro bereit, um das Zentralheiligtum der Grabungsstätte auf Frankfurter Stadtgebiet näher zu erforschen.

Ein Vierteljahr nach der Abspaltung von Continental kündigt der Zulieferer die Streichung von mehreren Tausend Stellen an. Auch die Zentrale in Frankfurt ist betroffen.

Genickbruch oder Jagd mit Falken: Manche sind bereit, im Kampf gegen Tauben grausam zu werden. Die Stadt Frankfurt geht den freundlicheren Weg – und hat eigens einen Taubenmanager beauftragt.

Eine Rentnerin möchte ihren zwei Söhnen ihre Immobilien vermachen. Allerdings sind die Kredite noch nicht getilgt. Und nun?

Der Markt für Elektroroller ist umkämpft – auch in Frankfurt. Die Stadt prüft daher ein Vergabeverfahren. Ungemach droht den Verleihern vom Bundesjustizministerium.

Das neue Passagierterminal am Frankfurter Flughafen wäre allein der fünftgrößte Flughafen in Deutschland. Damit zum Beginn im April alles klappt, werden die Abläufe mit tausenden Komparsen getestet.

Dem Städel gelingt der Ankauf eines der bedeutendsten Kunstwerke mittelalterlicher Bildhauerei in Deutschland – und eine Familienzusammenführung.

Zum Jahrestag der Befreiung des Vernichtungslagers Auschwitz erinnert Frankfurt an die Sinti und Roma in der Stadt. Die Resonanz ist groß.

Die Frankfurter Buchmesse bekommt einen neuen Geschäftsführer: Carlsen-Verleger Joachim Kaufmann folgt im Herbst 2026 auf Juergen Boos.

Psychotherapeuten werden gebraucht. Doch so lange es kaum Plätze für die erforderliche Weiterbildung gibt, kommt zu wenig Nachwuchs in den Praxen an. Das ist nicht das einzige Problem.
Die Diagnose „Glioblastom“ ist bisher praktisch immer ein Todesurteil. In Frankfurt wird demnächst ein Mediziner ausgezeichnet, dessen Forschung dies ändern könnte.

In Frankfurt liegen Gruseltouren durch die Stadt im Trend. Und im Rhein-Main-Gebiet plant man die Zukunft des Verkehrs, auch wenn diesen das Winterwetter mal nicht an den Rand des Stillstands bringt. Die F.A.Z.-Hauptwache blickt auf die Themen des Tages.

Agostino Steffani starb 1728 auf der Durchreise in Frankfurt. Jetzt hat man hier seine in Düsseldorf uraufgeführte Oper „Amor vien dal destino“ ausgegraben.

Ein heftiger Wintereinbruch hat am Montag in Hessen Straßen, Schienen und sogar den Flugverkehr lahmgelegt. Busse blieben stehen, Lastwagen blockierten Autobahnen, am Frankfurter Flughafen fielen fast 80 Flüge aus.

In Frankfurt ist bald Kommunalwahl. Die Fastnachter lassen das Thema weitgehend links liegen. Stattdessen regieren bei 7 × 11 Jahre Niederräder Carneval Verein Humor, Musik und jede Menge Herz.

Horrorfilme sind beliebt wie nie. Und auch gruselige Stadtführungen ziehen viele Besucher an. Unterwegs mit der Figur „Leonardo“ auf den Spuren des „Schwarzen Tods“ durch Frankfurt

Ortsbeiräte sind die Basis der Demokratie. Aber sie werden gerade in einer Großstadt wie Frankfurt oft von der Stadtpolitik übergangen. Vor der Kommunalwahl im März fordern die Gremien mehr Respekt ein.